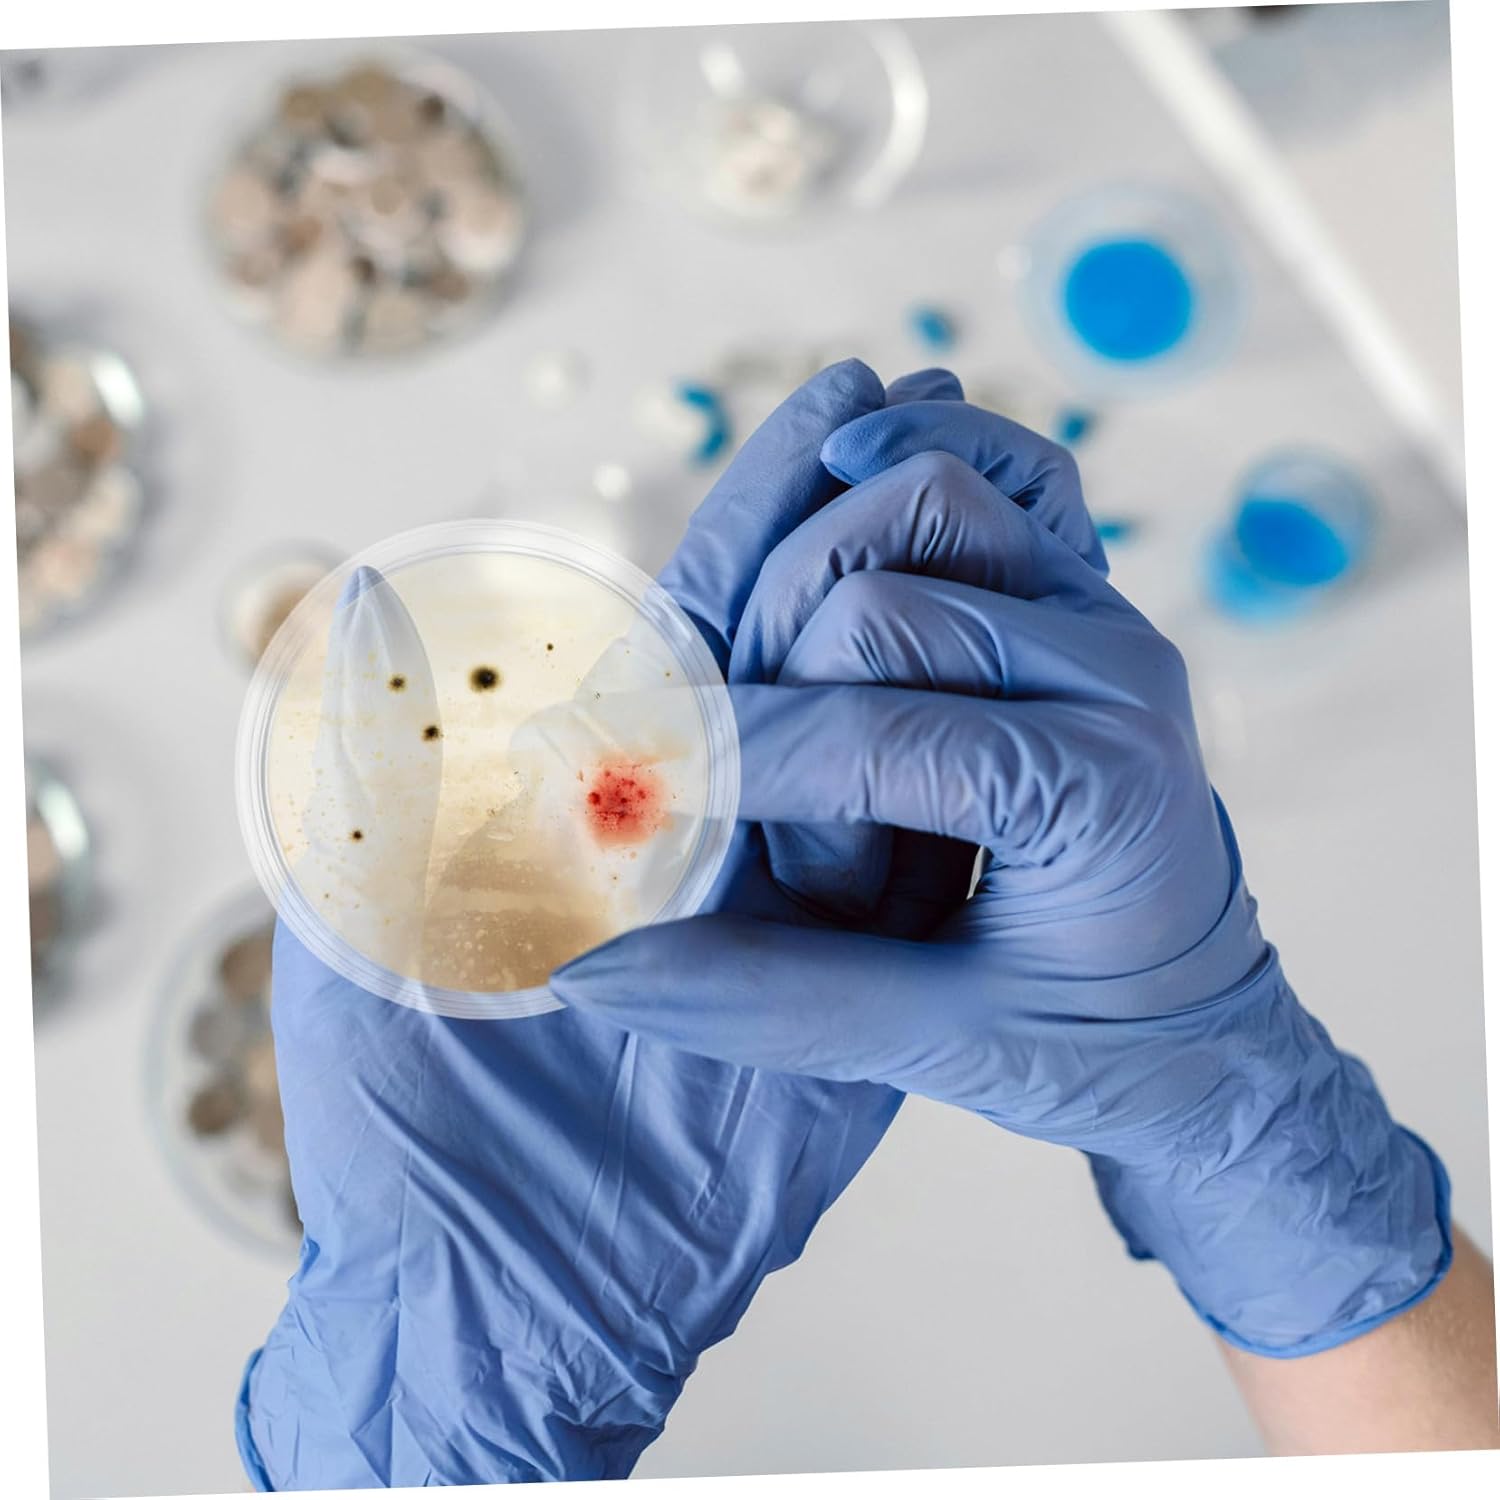

OUNONA 10pcs Educational Lab Accessory Glass Petri Dishes Lids for Science Projects Training
 Limited Time Sale
Limited Time Sale$19.01 cheaper than the new price!!
Free cash-on-delivery fees for purchases over $99
Product details
| Management number | 211013871 | Release Date | 2026/04/04 | List Price | $12.68 | Model Number | 211013871 | ||
|---|---|---|---|---|---|---|---|---|---|
| Category | |||||||||
Package List 10 x glass petri dishes Features - glass: made from borosilicate glass, these culture dishes are reusable and resistant to temperatures, providing durability for various lab applications petri dish -Clear microscopy: the optical clarity of these plates ensures precise and detailed observations during microscopic examinations, crucial for accurate research petri dish -Consistent cell : designed with a flat, smooth surface, these dishes promote uniform cell without clumping, and the vented lids ensure proper ventilation and protection agar petri dishes -Multipurpose: these dishes are great for laboratory training, science experiments, and even themed birthday parties, offering a wide range of educational uses science plates -Size:9.80X9.80X2.20cm/3.85X3.85X0.86in petri dishes -Material:Glass agar plates -Enhanced visibility: the clear, bubblefree glass allows for easy and accurate observation of samples under a microscope, making it ideal for mycological studies lab petri dishes - Color: Transparent laboratory culture dishGoods Descriptionpetri dish The 90mm diameter offers sufficient space for and observation, making them versatile for various experiments.agar plates The glass material is non-reactive and provides a environment for your samples. petri dish These culture vessels are suitable for a wide range of laboratory uses, including culture, tissue culture, and other scientific investigations
- Optical transparency: these plates offer optical clarity for detailed microscopic examinations, ensuring accurate and reliable experimental results,lab petri dishes,petri dish
- Microscopic precision: the optical transparency of these plates ensures detailed and accurate observations during microscopic examinations, crucial for research,science lab equipment,petri plates
- Clear observation: the high clarity of the glass, devoid of internal bubbles, facilitates clear and precise sample observation under a microscope, great for cultures, petri dish,petri dishes with lids
- Reusable : made from borosilicate glass, these culture dishes are designed for repeated use and can endure extreme temperatures, making them a reliable choice for labs,laboratory culture dish,glass petri dishes
- Educational tool: ideal for laboratory training, science projects, and themed parties, these dishes serve as an excellent educational resource,plates for laboratory use,culture plate
| Department | Unisex Adult |
|---|---|
| Item Weight | 1.92 pounds |
| Manufacturer | OUNONA |
| Item model number | 30806137YBCA6Q |
| Product Dimensions | 3.86 x 3.86 x 0.87 inches |
Correction of product information
If you notice any omissions or errors in the product information on this page, please use the correction request form below.
Correction Request Form

![[Autoclavable] 500 Pack Sterile Thick Plastic Petri Dishes with Lid, Vabiooth 90mm Dia x 15mm Deep Clear 3 Vents Petri Dish for Lab Science Experiment, Non-Fragile, Scratch-Resistant](https://m.media-amazon.com/images/I/71rIlty5EVL._SL1500_.jpg)